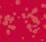

![]()









































































































































































Day 365 seems to come around faster every year and my first 240+ days as CEO have been truly inspiring. It’s been a year of listening, learning and doing, and I wanted to take this opportunity to share some of my reflections with you.
We have trained over 1,750 people in lifesaving CPR and effective defibrillator use across Devon this year through our Help with All Your Heart programme – read more on p4.
By the end of the year, our tenacious Fundraising teamalong with our fantastic volunteers - will have attended over 250 events, creating memorable moments and lasting connections with communities across Devon (p8-11).
Our ever-busy Retail team opened their 22nd shop this year, including a return to Tiverton high street (p12). As if dealing with the logistics of running 22 shops wasn’t enough, the team processed over 60,000 donations, while greeting over 263,000 customers!
Lastly, our incredible crews have been tasked to 1,446 missions so far this year, with 910 callouts handled by our helicopter crews and 484 by Critical Care Car. It is with this striking information in mind that I draw your attention to this year’s Christmas campaign, where we’re asking for your donations to help us continue to provide critical lifesaving on-scene treatment to patients, as well as support, comfort, and warmth throughout winter.
Thank you!

Greg Allen Chief Executive Officer









Cardiac arrest can happen to anyone, anywhere, at any time - and when it does, every second counts. That’s why learning CPR (Cardiopulmonary Resuscitation) and feeling confident using a defibrillator (Automated External Defibrillator, or AED) could make all the difference.

When someone goes into cardiac arrest, their heart suddenly stops beating effectively. Without immediate action, survival rates drop by around 10% for every minute that passes. But if CPR is started quickly and, where possible, a defibrillator is used - the chances of survival improve significantly.







We regularly host CPR and defib training events across the county as part of our ‘Help with All Your Heart’ campaign. These sessions are free to attend, and everyone is welcome to join us and learn these lifesaving skills.
Many people feel nervous about stepping in during a cardiac emergency, but the most important thing to remember is: you don’t need to be an expert to help save a life. Performing effective chest compressions - hard and fast in the centre of the chest - can keep blood flowing to the brain and vital organs until professional help arrives. It’s far better to try than to do nothing at all.




When it comes to using a defibrillator - just open the box...
Modern defibrillators are designed to be incredibly user-friendly. Once opened, the device will speak to you, guiding you step by step through the process.
It will tell you exactly what to do, including when and where to place the pads, and will assess whether a shock is needed. You can’t accidentally hurt someone with an AED; it will only deliver a shock if required.

We regularly host CPR and defib training events across the county























Knowing the location of your nearest AED can be lifesaving. Defibrillators are often found in public places like supermarkets, sports centres, schools, and community halls.
Did you know?
There are defibrillators located outside, or near to, all our charity shops.











































Before you approach the person who has collapsed, check your surroundings for danger.
1 Shout for help. Gently shake the person who has collapsed.



2 Look and listen for signs of normal breathing. Look for the rise and fall of their chest.


3 Call 999.

999
Put the phone on loudspeaker and tell them you are with someone who is not breathing.
4 Start chest compressions.
• Interlock your fingers.
• Place your hands in the centre of the chest.

The more people who are trained and confident in CPR and defibrillator use, the safer our communities become. We set an ambitious goal of training 2,025 people in 2025, and we’re pleased to have already trained over 1,750. It takes just a few minutes to learn, and you could be the reason someone gets a second chance at life.
Sign up to take part in one of our sessions:


• Push down hard and then release twice per second, and don’t stop.
• The ambulance call handler will help you.
5 Is there a defibrillator available?
The ambulance call handler will tell you where the nearest automated external defibrillator (AED) is. If someone is with you, ask them to fetch it and bring it back. Do not leave the person if you are on your own.
6 If you have a defibrillator, switch it on and follow the instructions. The defibrillator will tell you exactly what to do.
7 Continue CPR.
Continue giving CPR until:
• The AED asks you to pause while it reanalyses and gives another shock if needed.
• A paramedic arrives and tells you what to do.
• The person shows signs of life.












OOn the morning of April 3rd, 2025, Dean Stelloo did the same thing he’d done hundreds of times before. He got up early, made himself a coffee, had some breakfast, and headed out to work. It was a little earlier than usual - around 5:30am as he was due in Combe Martin to carry out a routine drugs and alcohol test on a construction site.
Just after 7am, Dean parked up and was chatting on the phone to his wife, Gemma, while finishing his coffee and waiting for the site to open. Once the site gates were opened, he told Gemma he was heading into work, promising to call her when he finished. A normal start, to another normal day.
Working in health and safety, Dean had recently championed the need for additional first aiders on his company’s construction sites, as well as mandatory defibrillators accessible to all workers.
“I felt absolutely fine all morning,’ Dean recalls. ‘But as I stepped into the canteen portacabin some time later, I suddenly felt light-headed and quite unwell. That’s the last thing I remember.”
Forward planning and preparation
Dean collapsed, falling hard onto the concrete outside the canteen, he was in full cardiac arrest. Colleagues rushed to his side, with one worker immediately beginning CPR before the site’s nominated first aider took over. First-aider, 24-year-old, Jack, remembers hearing Dean’s ribs break - but he didn’t stop.
A defibrillator was retrieved, amazingly, a device that Dean himself had taken to the site weeks earlier. The first shock was delivered, bringing him back momentarily, but he went into arrest again. Another round of CPR. Another shock. Dean’s life was hanging in the balance.
He was resuscitated twice before the ambulance arrived. He regained consciousness briefly in the back
of the road ambulance, asking if someone had called Gemma. Then he blacked out again, waking up in the air ambulance, and, true to his 23 years of Royal Navy service, commented on the flight helmets being used by the paramedics. The next thing he remembers is coming round again in the back of another road ambulance on his way into the hospital.
From there, it was a blur for Dean. Flashes of faces, hospital corridors, and conversations that didn’t feel real. “It was like a weird dream,” Dean says. ‘Everyone kept changing.’
He finally woke up in the hospital recovery ward and couldn’t understand why he was there. Doctors explained: he had suffered a sudden out-of-hospital cardiac arrest, surviving only thanks to the immediate CPR and defibrillation he had received on site. But he felt fine, albeit hungry, and desperately wanting to go home.
For Gemma, the experience was no less intense
“We’d just spoken on the phone 20 minutes before,” she says. “Then the call came, and I couldn’t take it in. I heard the paramedic, but I was in disbelief. I just kept asking, Are you sure it’s Dean?’’
Gemma faced an hour-long drive to Exeter Hospital, not knowing what or who she’d find. “The relief of walking around the corner and seeing him sat up in bed, smiling and saying, here she is! - I just broke down. I’d imagined the worst.”
““We need defibs on every site - no matter the size or how long we’re there,” he had said. It was the same defib that ultimately saved his life.










The next few weeks were surreal. With three young children at home, Gemma found herself on autopilot, juggling hospital visits and keeping life as normal as possible for the girls. Dean stayed in hospital for three weeks, constantly insisting he was fine and ready to go home.
The impact has rippled far beyond that day Dean is now fitted with an ICD (Implantable Cardioverter Defibrillator), and, as a result, has been temporarily banned from driving while he gets used to this new device. Apart from this adjustment, his recovery has been remarkably swift - even passing the treadmill test in hospital with flying colours.
Despite this swift recovery and the remarkable circumstances in which Dean’s life was saved thanks to the actions of his colleagues and the fortuitous delivery of a defibrillator on site, the emotional processing continues for Dean and his family.
“We’ve talked about it so much,” Gemma says, “but the emotions are still confusing. The ‘what ifs’ are the hardest part.”
Dean agrees. “If I’d known what was going to happen, I probably would have kissed my girls goodbye that morning. But I didn’t.”
That defibrillator on site? Dean had made sure it was there, raising concerns in a company safety forum just before Christmas. “We need defibs on every site - no matter the size or how long we’re there,” he had said. It was the same defib that ultimately saved his life.
Since the incident, both Dean and Gemma have become passionate advocates for CPR training and access to defibrillators. Dean had created a presentation on cardiac arrest awareness whilst in hospital and used this to demonstrate the importance across his workplace and
other organisations - including Babcock in Bristol, where Gemma’s brother took the message further.
Even their children now know where the nearest defibrillators are in their local village. “We were lucky that day,” Dean says. “It happened in a town centre. But I work in remote locations - any other time, I might not have been so close to help. That’s why services like Devon Air Ambulance are vital.”
Commenting on the colleagues who stepped in and saved Deans life, Gemma said, “For such young lads to do such a massive thing… that’s going to impact them forever. It’s changed our lives, and I know it’s changed theirs too.”
Sometimes, surviving isn’t just about luck. It’s about preparation, action, and the people who refuse to give up.
Have you been assisted?

If we’ve helped you or a family member and you would like to share your story with us, please complete the form at the website address below or scan the QR code and a member of our team will be in touch.
daat.org/your-story







































As the curtain falls on what has been the most remarkable year yet for Devon Air Ambulance’s running community, 2025 has once again proven the strength, spirit, and solidarity of our incredible supporters. From the rugged coastlines of Devon to the iconic streets of London and Berlin, runners
Tudor Morgan-Huggett signed up for the Berlin Half Marathon on 11th April 2024 as part of his goal to complete the SuperHalfs series – six races across Europe, including Cardiff, Berlin, Copenhagen, Lisbon, Prague, and Valencia. He had already completed the Cardiff leg in October 2023 and was excited for the journey ahead.


Just six days later, a football injury resulted in a fractured tibia requiring surgery with a titanium rod, pins, and plates. Despite this major setback, Tudor remained determined to recover in time. Through months of physiotherapy, home exercises, swimming, and gradual treadmill and outdoor running, he made remarkable progress.
Tudor successfully completed the Berlin Half Marathon in April 2025 – a milestone he describes as both emotional and rewarding. Running in support of DAA, a charity close to his and his employer’s heart, Westexe Forklifts Limited, he raised an incredible £3,213 in memory of their much-missed colleague, Geoff Mudie. Tudor now looks forward to continuing his SuperHalfs challenge with renewed motivation.



of every pace and background have laced up, shown up, and made every mile count - raising an astonishing £17,700 (and counting) for our lifesaving charity.






Devon Air Ambulance has been proudly represented in races across the county, the country, and beyond. From Plymouth, Exeter, Teignmouth, Barnstaple, Bideford, and Paignton, to Bristol, Newport, Manchester, Brighton, London, and Berlin - our runners have flown the DAA flag far and wide.


Running in support of DAA, Tudor raised an incredible £3,213



























































































2026 promises to be even bigger than this year, as runners take part in top races across the country, including our first-ever charity places at the iconic TCS London Marathon in April.
As global audiences tune in to watch the race unfold, we’ll be cheering on Team DAA – and who knows, you might even spot our runners on screen! On race day, we’ll also be opening applications for our 2027 London Marathon team, giving even more runners the chance to represent a cause that saves lives.

See you on the start line!







A heartfelt thank you to our incredible coach, Corin, from Run Fit Run Fast, and to City Runs for their unwavering support throughout 2025hosting races that proudly championed our cause across the region. Their dedication has helped turn every mile into a mission.
into a mission.













If you’re ready to run with purpose in 2026 - whether you’re aiming to secure a charity place, host a race in support of DAA, or simply want to be part of something extraordinary - scan the QR code, fill out the form, and a member of our team will be in touch.




As we reach the end of another fantastic year of fundraising, we’re taking a moment to reflect on some of the incredible events that have taken place this year and, more importantly, to thank you, our supporters, for everything you’ve done to help keep our crews responding.
From cakes, to daring descents and 26-mile hikes, this year has been filled with energy, community spirit, and a shared commitment to helping save lives across Devon.





Here’s a look back at just some of the highlights.
5 July 2025
The day over 130 walkers joined us on the stunning South West Coast Path for our first ever Devon Heli Hike. Taking on challenging 14 or 26 mile routes, our hikers banded together to tackle this gruelling event, putting one foot in front of the other to raise an incredible £45,000+ for our cause. A huge thank you to everyone who joined us on the day to hike, and to volunteer or donate.
Take part in Devon Heli Hike 2026 – sign up here! daat.org/Helipad-hike-26










Back for its second year, Bake Off for Take Off saw individuals, clubs, companies and schools whipping up a storm in the kitchen. Whether you baked at school, at work, or with friends and neighbours, your efforts turned flour and sugar into funds that make a real difference, raising £6,532 so far.


















August saw us bouncing around an inflatable course at Westpoint. As headline charity partner, we were thrilled to welcome 150 Devon Air Ambulance runners (or should that be ‘jumpers’?) to the event. We saw families and their tots taking on the 2.5k course, and adults enjoying the 5, 10 and 15k routes!
Thank you to all our bouncy fundraisers, who collectively raised over £11,000!
2025 marked the 13th Exeter Round Table Fireworks Extravaganza. The display returned this year with a spectacular Halloween theme by British Firework Champions, Sonic and was hosted by Radio Exe. It was a sensational evening of fun, food and a dazzling display, all in support of DAA.



We’d like to extend a heartfelt thank you to Exeter Round Table and their sponsors. Over the last 13 years, the event and partnership with ERT has raised approximately £100,000 for our vital service.






































Returning for its second year at two incredible locations across Devon: Mount Batten in Plymouth and Meldon Viaduct near Okehampton.








Our brave fundraisers faced their fears and stepped over the edge, all to support Devon Air Ambulance.







Looking back, we are so thrilled with how the last year of fundraising has turned out! Every cake baked, mile walked, obstacle tackled and abseil rope gripped contributed directly to our lifesaving mission.
As we head into a new year, we carry your support with us. From all of us at Devon Air Ambulance, thank you.


























Nestled at the meeting point of the Rivers Exe and Lowman, Tiverton is a town steeped in history and brimming with community spirit. Once a powerhouse of the medieval wool trade and later a centre of lace-making innovation, Tiverton has always embraced change while honouring its rich heritage.
From the grandeur of St. Peter’s Church to the elegance of Knightshayes Court, the town’s landmarks tell stories of resilience and reinvention.
And it is with this ‘resilience and reinvention’ in mind that Devon Air Ambulance makes its return to Tiverton, with the opening of our new retail shop in the town’s centre. This bright new chapter offers a chance for us to reconnect with a community that has long supported our mission, while offering fantastic opportunities for locals in the area to get involved and support our work.
A fresh start on Fore Street
After saying goodbye to our Market Walk shop in 2017, we’re thrilled to have returned to Tiverton with a brandnew retail store. Located on bustling Fore Street, the shop
has already received a warm welcome from locals - and we couldn’t be more grateful.
But this isn’t just a return; it’s a reinvention, blending our much-loved, traditional charity shop format with a dedicated Outlet section. Previously only available in Exmouth, these Outlets offer even more variety for shoppers, more chances to save money and more opportunities to support our lifesaving work.
Open six days a week (Monday to Saturday), whether you’re browsing for a bargain, dropping off donations, or curious about how you can get involved, our friendly team is always ready to help.
Rooted in the community
Devon Air Ambulance has long been a part of the fabric of Mid Devon life, and our return to Tiverton is a celebration of the incredible support we continue to receive from the community.
We are honoured to be the chosen charity of Tiverton’s award winning, Mid-Devon Show, an annual event that
celebrates the very best of rural life. Here you will find an array of delicious local produce, alongside suppliers from across the county and, if you’re lucky, our crew and cuddly mascot Ambrose!
Our work is also championed by inspiring locals like Debbie, a former patient who ran 60 marathons in her 60th year, raising over £4,000; and Rose Chanin, who leads the Bickleigh Drama Group, raising nearly £30,000
We’re always looking for enthusiastic, communityminded people to join our volunteer team. Whether you’re greeting customers, sorting donations, or creating eye-catching window displays, every role makes a difference.
Volunteering with us is a great way to:
• Gain hands-on retail experience
• Build confidence and new skills
• Meet new people and make lasting friendships
• Support a cause that saves lives across Devon
No experience? No problem.
All you need is a positive attitude and a few spare hours—we’ll provide all the training and support you need!
through annual performances. Their dedication, along with countless others, keeps our crew responding.
And our Tiverton store is more than just a place to shop. It’s a space where community connections are made, where every purchase and donation supports our vital emergency service, and where volunteers play a central role in making it all happen.

Sara & Chris Bellworthy
“We moved to Tiverton in 2013 and were welcomed into the community. After Chris was airlifted following a motorbike accident in 2015, we began volunteering with Devon Air Ambulance delivering community talks. I now also help in the Tiverton shop and love meeting so many wonderful people. It’s a joy to be part of something that gives back to the town we call home.”
Wendy Sweet
“After retiring in 2024, I was looking for something meaningful to do. When I heard about the new shop, I signed up straight away. I love volunteering on the till and chatting with customers. The shop is bright, welcoming, and full of great finds. It’s a lovely way to stay connected to the community and support a cause I care about.”


Whether you’re shopping, donating, or volunteering, our new Tiverton shop is a place where everyone can make a difference. We’re proud to be back in this historic town - bringing new energy, new opportunities, and the same unwavering commitment to saving lives across the region.
Our crews have attended
*As of 01/09/2025 incidents in Tiverton so far this year.
Have you ever wondered how we’re able to keep our helicopters and Critical Care Cars operating?
As an independent service, Devon Air Ambulance depends on support and kindness from people who choose to donate to us. With a gift in your Will, you can help secure vital care for someone, when it’s needed most at no cost to you today. You can leave a gift of as little as 1% in your Will, enabling our expert clinicians to continue delivering a compassionate service when specialised care is urgently needed - in remote parts of Devon, and when every second counts. Your gift could help make the difference to someone who urgently needs our support.
Last year alone, our crews responded to 2,459 missions. A massive 819 of those were made possible by gifts



in Wills. In addition to Devon Air Ambulance’s regular operations, our Volunteer Responders were tasked to a total of 101 missions. These specialist paramedics volunteer their free time while off-duty to assist patients across the county.

And none of this would be possible without your valuable support!
Your gift could also fund crucial advanced medical equipment, keeping our helicopters fully equipped with the latest technology, and supporting further training for our staff in prehospital critical care skills.
Last year alone, our crews responded to 2,459 missions. A massive 819 of those were made possible by Gifts in Wills.


Leaving a gift in your Will is profoundly powerful. It’s a way to ensure your values, or those of your loved ones, live on as part of the Devon Air Ambulance story.
If you are considering leaving a gift in your Will, we’d love to help. Email YourWishes@daat.org and a member of our friendly Gifts in Wills Team will be glad to assist you. Or visit our website for more information.
• We have a free Wills & Legacies guide on our website to help get you started
• You can leave from as little as 1% of your estate to Devon Air Ambulance and make an extraordinary impact
• You can gift cash or any item of value in your Will
• You only need to provide your solicitor with our charity number, name and address – it really is that easy





P.S Your future gift ensures our helicopters and critical care cars are crewed, fuelled and ready to respond when we are needed most.
Make your gift count today, and your legacy will last beyond tomorrow!




As the days get shorter and the weather gets more unpredictable, we’re here to provide you with some inspiration and ideas to help you fundraise during the winter months.

Get involved from the comfort of your own home by indulging in your hobbies, getting crafty or keeping warm with activities that will get your blood pumping!













Lace up your trainers and grab your Santa hats, reindeer antlers and elf ears for a festive themed fun run. Jog, walk or dash through a course of your choosing while spreading some festive cheer.





























Turn your hand to some creative Christmas crafts and sell them locally to friends, family and colleagues. Handmade gifts and accessories can make the festive season extra special – from cards to gift tags and wreaths to wrapping paper.

























Dig out your most spectacular Christmas jumper and wear it with pride for a sponsored Christmas Jumper Day. Whether it’s covered in tinsel, jingling with bells, or so bright that it lights up the room, this simple fundraiser is great fun for colleagues,
Jumper Day. Whether it’s covered in tinsel, jingling friends and family!














Games are a great way to keep yourself entertained while it’s cold and dark outside. Up the ante and set yourself a challenge by raising money while you play! Video games, jigsaw puzzles, chess – whatever your game of choice, there are lots of different ways to turn games into great fundraising opportunities.

























Dazzling Christmas light displays are a fantastic way to muster some festive cheer in the community at Christmas. Invite those in your area to come and enjoy some fundraising sparkle at night. The Dunn Family Christmas Lights have been illuminating Bonville Cresent in Tiverton for 25 years in support of our work. They will be switching the lights on for the final time on Sat 29 Nov with stalls from 6pm and light switch on at 7pm. Help them make this a year to remember by showing your support!
PS. A massive thank you to Janet & Paul for all of their hard work over the years.












We’ve adapted our popular pub quiz for Christmas! Sign-up to receive a fun filled festive quiz that you can take part in with your friends, colleagues or by hosting an event at your local pub in support of DAA. Need more of a challenge? We also have 30 pre-written rounds, ready to go. Visit: daat.org/pub-quiz





























Join us in St Marychurch from 6-8pm on December 4th and Exeter on December 14th 10:30am – 12:30pm for a fun and festive wreath making workshop! Visit daat.org/events for full details









Whether you’re a seasoned baker or a kitchen novice, organise a festive fundraiser that makes a difference and indulge in some sweet treats at the same time. From mince pies to Christmas cake and yule logs to perfect panettone, host your very own Yuletide Bake off for Take off and raise funds to keep us flying this winter. Visit: daat.org/bake-off






















across the county. Your inspirational fundraising efforts keep our crews responding, seven days a week, 365 days a year - demonstrating that we are all,



Every year in May, Shebbear United Football Club hosts a charity football match in memory of Roger Marshall, who tragically died in 2021. A keen football fan, Roger’s friends, family and the community come together to keep his memory alive. Roger’s wife, Leanne, said, “Roger’s good friends Ian Luxton and Mike Edge came up with the idea. It’s our way of remembering a wonderful husband, father, son, brother and dear friend to many, and to raise vital funds for a charity and services so very close to our hearts.”









Colyton Youth Football Club, in partnership with Axe Valley Runners, raised an impressive £1,000 with their ‘ColyTen Run’, a 10-mile multi-terrain run. U12’s Manager and Club Chairman at Colyton Youth Football Club, Jody Tucker, said, “We were honoured to contribute to a charity that touches so many lives across Devon. We all pray that we never need the helicopter, but we are eternally grateful that it is there for everyone if needed, and knowing our efforts help keep this lifesaving service flying is truly inspiring for everyone involved. Thank you all for everything you do.”







Danny £1,400


Best friends, Joel and aged 10 and 11, took on their biggest challenge yet by completing a 10k run in April. This was the furthest the boys had ever run and, after weeks of dedicated training, they proudly crossed the finish line—raising an incredible . A truly inspirational effort!

















Devon Air Ambulance was honoured to be chosen as one of two beneficiaries of the Torquay Golf Club, Annual Charity Pro-Am event which raised £2,020 for DAA. Volunteers Lesley and David Roberts, along with Carol Willoughby (pictured), proudly represented the charity on the day, raising vital awareness and supporting the Club’s fundraising efforts.
The Hot Pins Knit & Natter Group from Crediton have been busy with their hooks, creating adorable, crocheted teddy bears. Raising £846 through the sale of these cuddly creatures.




























Inspired by her love of our St Marychurch shop - her very own “little treasure trove”Constance Spooner turned creativity into kindness. Handcrafting and selling jewellery at school, before completing a sponsored walk from Haytor to Hound Tor with her dad, she raised an impressive £351. A huge effort from a young fundraiser with a big heart.















Following a visit from DAA volunteers, Marilyn and Alan MacQueen in April – students from Clawton Primary School have been working towards becoming ‘Inspiring Changemakers’ and one of their challenges was to become, ‘Inspiring Fundraisers’, raising £145 by making and selling delicious cakes!





















Long-time supporters, Lyn Line Dancers, have once again stepped up for Devon Air Ambulance - donating an incredible £1,479 this year through their tireless fundraising. We are truly grateful for their continued commitment and community spirit.







Regular supporters Carol Swiecicka and her husband, Richard, ran a popular cream tea event with the Newton Abbot Travel Club at the Livermead Cliff Hotel in Torquay and raised an amazing £500. Some of the club members dressed up for the occasion, as entertainment was performed by Elvis tribute act, James Burrell. club



















Hobbyist, Dave Easter from Plymouth, crafts beautiful woodwork pieces, each with a distinctive, eyecatching style. These range from decorative platters, vases and goblets to arty items and more, designing many on request - a true craftsman! Sales go to his charity of choice, and, to date, he has raised a fantastic £500 for Devon Air Ambulance!











Thank you to Sorcha Disbrey who took part in the Bleinheim Palace Triathlon and raised an amazing £960





SUN 23 NOV





































































































s the festive season draws near, many of us cherish the thought of cosy evenings, twinkling lights, and precious moments with friends and family. It’s a time filled with warmth, generosity, and reflection. But for patients caught in the grip of sudden, life-threatening emergencies this winter, those simple joys can vanish in an instant.

At Devon Air Ambulance, we know that our response time is paramount when dealing with a sudden injury or illness, because every second counts. But it’s also vital that we keep our patients as comfortable as possible, during what could be one of the worst moments of their life.

Imagine being injured in a remote location, exposed to the elements while waiting for help. Or think of those who struggle to keep warm during the colder months — these are real challenges faced by some of our patients.


































When someone is critically ill or injured - in their own home or a rural environment - the winter months make these scenarios more challenging than usual. Patients may find themselves unable to move on cold ground, while exposed to wind, rain, or snow and it’s during these moments, that small acts of care and compassion can make a big difference.












As a charity that relies on donations from kind supporters and businesses, we simply couldn’t continue to provide our lifesaving service without your support. That’s why, this Christmas, we’re asking for your help to bring comfort at Christmas to those who need it most.















Our crews are trained to deliver advanced, hospitallevel care at the scene of an incident. But they also carry essential items that offer warmth and protection, helping to preserve dignity and comfort in moments of vulnerability.




Cold patients who have been subject to serious trauma are at higher risk of bleeding; this means that there is a more vital reason to keep patients warm as well as bringing comfort.



















































This winter, your support will help us fund vital items and equipment that make a real difference:

£6 could purchase a newborn baby towel - a specially sized towel to swaddle very young patients



















£20 could purchase blizzard blankets - to fully wrap around the patient, keeping them warm and protected

£30 could purchase heated blankets - automatically warm up to keep patients warm during transport





£295 could purchase a unit of LyoPlas - an essential dried blood product for trauma patients







£985 could purchase a Scoop Stretcher - lifts patients and isolates them from freezing ground









Warm beanie hats are kindly knitted and donated to us by our incredible supporters who truly make a difference!

Each item on our Comfort Shopping List is more than just equipment - it’s a gift of compassion.
Whether you choose to sponsor a single item or a full Comfort Kit, your generosity will directly impact someone’s experience in a moment of crisis.











Beyond the emergency response, our Patient & Family Support Team continue to provide care long after the helicopter has landed. From hospital visits to emotional support, guidance and signposting, our team ensures that patients and their families feel seen, heard, and supported throughout their recovery.




This holistic approach to care is what makes Devon Air Ambulance unique. We don’t just treat injuries; we care for people. And that care extends to the smallest details, like making sure a patient is warm, dry, and comforted in the midst of trauma.































Operations Manager and Prehospital Paramedic, Mark, tells us how a little warmth can go a long way.
As someone who has been on the front line of emergency care for many years, I’ve witnessed firsthand the difference that a little comfort can make to our patients and their families. When we arrive at the scene of an incident - whether it’s a road traffic collision, a medical emergency at home, or a fall in a remote location, our priority is always to deliver exemplary critical care. Part of this exemplary care involves doing everything that we can to ease suffering, to add a sense of calm amid chaos and to bring warmth to patients in their most vulnerable moments.
That’s why I’m asking for your help in bringing comfort to patients this Christmas.











Devon Air Ambulance is entirely funded by the kindness of people like you. We receive no direct government funding for our lifesaving service, which means every mission, by air or by road, is made possible only by donations, fundraising, and gifts in Wills. It’s a service we all hope we’ll never need but simply knowing that we’re here brings peace of mind to communities across Devon and beyond.
This Christmas, please consider giving a gift that will bring comfort to those in need. Your donation could help to save a life and bring warmth to someone in their darkest hour.
The items listed in our Comfort at Christmas campaign may seem simple, but they’re powerful. They help us to care for a person and not just their injuries.












Help us wrap patients in warmth and compassion this Christmas




























Last year, we treated Zoe and two of her friends who were seriously injured in a road traffic collision. Her story is one of resilience and recovery, and it reminds us how important comfort can be in those moments of high-emotion following a traumatic event - read more about Zoe’s story in the following pages >>>



This Christmas, we invite you all to be part of our mission. Your donation could help us stock our helicopters and critical care cars with the items that bring comfort to patients in their hour of need. Whether it’s a heated blanket or a weather shelter, every contribution helps us wrap patients in warmth and compassion.









Whether you’re donating in memory of a loved one, giving as part of a family tradition, giving back as someone who has experienced our service first hand, or simply want to make a difference this Christmas, your support means the world to us and to the patients and communities we serve.














our service first hand, or simply want to make a difference this


Every pound raised helps us prepare for the colder months ahead, ensuring that our crews are ready to respond with both clinical expertise and compassionate care.




































A birthday drive turned into a life-threatening crash for Zoe, who survived thanks to quick action, kind strangers and Devon Air Ambulance. Her recovery continues, assisted by a donkey named Merlin...
ast year, friends Zoe, Hannah and Kirsty, who all worked together at The Bedford Hotel in Tavistock, were on the way to their manager’s 40th birthday party. Travelling along the A386, the mood in the car was light-hearted and traffic was minimal. But, in an instant, everything changed. A devastating crash occurred when an oncoming vehicle collided with their car, leaving Zoe with multiple life-changing injuries, including nine broken ribs and a torn bowel.
“I managed to get out of the car,” Hannah recalled, “but Zoe was trapped, writhing in pain and clutching her stomach. It was supposed to be a gentle, fun evening but everything changed so quickly.”

initial assessment and treatment at the roadside. Zoe was airlifted to nearby Derriford Hospital in Plymouth, while Hannah and Kirsty were transported by land ambulance.
Zoe later said that her seatbelt saved her life, along with the quality and speed of care that she received from Devon Air Ambulance. Amid the chaos, kind strangers from a nearby campervan rushed to help, offering Hannah a duvet to keep her warm - their compassion providing great comfort amid such trauma.
Zoe later said that her seatbelt saved her life, along with the quality and speed of care that she received from Devon Air Ambulance. Amid the chaos, kind strangers from a nearby campervan rushed to help, offering Hannah a duvet to keep her warm - their compassion providing great comfort amid such trauma.

Because of the severity of Zoe’s injuries, Devon Air Ambulance was immediately dispatched. Our crew brought their critical care skills to the scene and after an
“I can’t remember the take-off or landing,” Zoe said, “but the sound of the rotor blades is etched in my memory.” Once admitted, Zoe underwent a CT scan and was sent straight to the Intensive Care Unit (ICU), where she spent four gruelling weeks.

Zoe’s condition was critical, and it quickly became clear that her injuries were extensive. She required emergency surgery and intensive care, with resulting complications affecting her breathing, circulation, and internal organs.
Her recovery has been long and challenging. Zoe now lives with lasting physical effects, including scarring, reduced mobility, and ongoing health issues that prevent her from returning to the active lifestyle she once enjoyed - including running and taking part in the sports she loves.
While Zoe, Hannah and Kirsty all recovered, Devon Air Ambulance’s Patient and Family Support Team were there to provide support. Adrian from the team paid
























Hannah a visit just three days into her hospital stay. “Adrian was incredibly kind,” Hannah shared. “He sat with me, talked, and provided so much information and reassurance. It made a world of difference.”
Zoe echoed the sentiment: “That further support was just amazing. Adrian, and everyone at Devon Air Ambulance have been so generous with their time, even now, a year later.” Hannah added, “I want people to know how incredible the support is. Without it, I would have felt so lost.”
But the story doesn’t end there, and it wouldn’t be complete without a sprinkle of Christmas magic.

Knowing Zoe’s love for animals, her colleagues gifted her a donkey named Merlin. “It was such a thoughtful, caring gesture” Zoe said. “Having Merlin has been a huge part of my recovery. He’s amazing!”
“I go down to Billy’s farm most weekends and spend some time with Merlin. This really helps me to keep active, and every single person who meets Merlin tells me that he brightens their day. He does that for me and has been so important over the last year of recovery.

Whilst in hospital, Billy’s mum also made Zoe a beautiful crochet blanket to help her feel warm and comfortable. Zoe said, “Everyone who saw it in hospital, and still now at home, thinks it is stunning, and I agree!”
In February this year, the trio organised a fundraising coffee morning at The Bedford Hotel. The event raised over £3,000 and was filled with coffee, cake, and community spirit. Hundreds attended, a testament to the gratitude and the generosity of the local community.


Over a year on and Zoe is still recovering from her injuries and remains involved with Devon Air Ambulance, helping with research into road traffic injuries and sharing her story to raise awareness.







































Your support keeps us responding. From towns and cities to rugged coastlines and the moors.












Dr Clare Bosanko taking on the Devon Heli Hike





on the challenge
Beachfront Training with HEMS Technical Crew members, Martyn & Aaron



When every second counts, there are exceptions to the rule.



























































Intrigued onlookers watch as engineer, Jeff Glover, undertakes surgery on GDAAS.






Our crew can access anywhere in Devon within 15 minutes.



































Continuing Airworthiness Manager, Michael, took time out from his regular maintenance schedule to talk about his globetrotting career and how it led him to DAA.
ichael Snowden’s journey to becoming our Continuing Airworthiness Manager is rooted in decades of hands-on experience, global deployments, and a deep understanding of helicopter engineering. After leaving school at 16, Michael joined the Royal Air Force as an apprentice, where he spent three years in engineering training before embarking on a 22-year military career - entirely focused on helicopters.
“I started as a technician, then moved on to running trade desks,” he explains. “By the time I left, I was managing a shift of 60 people and 20 helicopters.” His RAF service took him across the world, including deployments to Northern Ireland, Kosovo, Bosnia, Iraq, Afghanistan, and Norway - where he endured Arctic survival training in -30°C conditions.
After leaving the military, Michael transitioned to civilian aviation before joining DAA, where he now oversees the maintenance of our two helicopters: G-DAAN and G-DAAS, ensuring that both helicopters are always ready to respond to emergencies.
Each day begins with a review of the previous day’s ‘flying returns’information supplied by pilots. “It’s like a logbook,” Michael explains. “I use it to track upcoming maintenance and make sure we don’t overfly any limits.

Everything is logged - hours, landings, engine cycles - and that data drives our planning.”
Each aircraft is subject to over 1,200 individual maintenance tasks. “There are checks every 15 hours or seven days, and others that are annual or even longer-term. It’s my job to make sure nothing is missed.” When things do go wrong, Michael is often the first to respond, but sometimes that’s not possible. “Last year, G-DAAS landed at Derriford and oil was running down the side. A pipe had come loose on the engine. We had to get engineers out to fix it on site. That kind of issue gets reported back to the engine manufacturer, and they’re now working on a modification.”
Other issues are more subtle. “The gearboxes have magnetic probes. If metal comes off inside, it sticks to the probe. If it’s big enough, it completes a circuit and alerts the pilot. If it’s smaller, it still sticks—but we have to inspect it manually. It’s a clever system, but it relies on us being vigilant.”
“There are checks every 15 hours or seven days... It’s my job to make sure nothing is missed.


Michael also plays a key role in budgeting and cost control. “We pay around £11,000 per month per helicopter for maintenance labour, and parts are extra. This year, each helicopter’s annual maintenance cost around £100,000 during inspection.”
“I maintain a five-year plan, so our finance team knows what’s coming. For example, a main gearbox costs £700,000 and is due in 2031. That kind of foresight helps us prepare and avoid surprises.”
From managing inspections and responding to technical faults, to saving the charity thousands through careful oversight, Michael’s role is central to our ability to deliver lifesaving care.
“It’s a modern aircraft with all the bells and whistles — four-axis autopilot, advanced avionics — but from an engineer’s point of view, it’s still nuts, bolts, and washers. You take things apart and put them back together. The key is doing it right, every time.”

Though the incidents we attend often make the headlines, our pilots and clinicians see themselves simply as professionals doing the work they are trained for.
Of course, for our patients, these moments are anything but ordinaryoften among the most challenging days of their lives. When one of our aircraft lands at the scene, or our crew arrives in a Critical Care Car, the presence of our skilled clinicians can feel nothing short of heroic.
Yet, we rarely hear from the crew about the experiences that have shaped them. Naturally private, they prefer to focus on anticipating and responding to patients’ needs rather than stepping into the spotlight. But with the support of North Devon photographer Paul Martin, that has changed.
Into the frame
Paul approached us with a generous offer: to professionally photograph our crew as a gift to the service. He met several team members at our Eaglescott airbase, interviewing them about their work and inviting them to reflect on the moments that have defined their careers. Through Paul’s lens, we glimpse not only the urgency and trauma our crews face,
In tandem with the portraits are our crew’s individual stories available on our website. They talk about the calls that changed them, the patients they’ll never forget, and the humour that keeps them grounded.
As Rhiannon, our Operations Manager, reflects:
“A patient once said, ‘I don’t
but also the camaraderie, resilience, and quiet strength that sustain them.
The resulting collection, It’s Who We Are, is being exhibited in communities across Devon, now and into next year. This touring exhibition invites residents and visitors alike to see our crew as you may never have seen them before.

Renowned for his editorial and reportage style, Paul donated his time and talent to this project. His portraits are more than images - they are windows into the emotional terrain our crew navigates every day. Our clinicians and pilots face the unimaginable, and Paul has captured that reality with sensitivity and depth.

remember what you said, but I felt safe.’ That meant everything. Sometimes, it’s not the words - it’s how we make people feel.”
And from Rob Taylor, one of our pilots:
“A parent once told me, ‘I was so relieved when I heard the helicopter.’ That sound - it means help is coming. It means hope.”
The photography will visit exhibition spaces across Devon, and we warmly invite our supporters to get to know the people behind the uniform.
Find out where the exhibition is visiting and read the crew’s stories at: daat.org/more-about-who-we-are

A research and innovation centre that aims to reduce road deaths and serious injuries was launched in June, at an event that brought together experts in road safety, research and emergency care.
Founded by our Critical Care Doctor, Professor Tim Nutbeam, IMPACT is the Centre for PostCollision Research, Innovation and Translation, which started operating in September last year, after much development and research work. IMPACT brings together a wealth of clinical and research experience and combines it with our commitment to innovation.
What’s more, this cutting-edge project is entirely grant-funded, meaning that public donations to Devon Air Ambulance continue to support our frontline operations.
Devon has one of the highest rates of serious road injury in England when adjusted for population. Every year, we respond to around 200 serious road traffic collisions, and more than half of the trauma patients we attend are injured on the roads. Devon also has the highest rate of medical events at the wheel in the country, and is among the worst areas for road injury involving children and young people.
Professor Tim Nutbeam, said, ‘While road injury is a global issue, the need for action is deeply local. IMPACT was created because we
know more can be done to prevent serious injury and to give every patient the best possible chance after a collision.’
Globally, road traffic injury is the leading cause of death for people aged five to thirty. Yet, it often goes underfunded and under-researched compared to other health priorities. Professor Nutbeam continued, ‘IMPACT is helping to change that narrative, starting right here in the South West.’
Since beginning work in late 2024, IMPACT has been nominated for national awards, delivered leading research and has collaborated closely with Vision Zero South West, the Road Safety Trust and international partners to drive change in the way road traffic collisions are responded to.
IMPACT’s mission is to generate new knowledge, develop practical solutions, and translate research into better care, both locally and internationally. ‘We’re building a Centre of Excellence in postcollision care, rooted in Devon but with global reach. The work we do here will influence practice not just in the South West, but around the world.’

“While road injury is a global issue, the need for action is deeply local. IMPACT was created because we know more can be done to prevent serious injury and to give every patient the best possible chance after a collision.








IMPACT exists to further the scientific study of factors which affect patient and bystander outcomes following road related trauma.
Scientific research focused on post-collision care
We believe that continuous advancement in medical technologies and care practices is essential to improving patient outcomes

The translation of research findings into real-world applications is an essential aspect of our centre’s work improving patient outcomes

For five years we’ve led a research and audit initiative involving all air ambulances in the UK. This collaboration brings researchers together, strengthens the results of studies and ultimately improves our service in Devon.
Cardiac arrest is one of the most serious emergencies our crews respond to. To help improve outcomes for patients, we recently took part in a national clinical study exploring different approaches to treatment at the scene.
Throughout 2023–24, paramedics played a key role in the research, recruiting some of the highest numbers of patients in the country. Their involvement is helping to shape future care and ensure that patients receive the best possible support when every second counts.

• Exploring how the public can provide help before emergency crews arrive - see below

• Improving post-crash care through national and international collaboration, including work on consensus guidelines and standards

• Sharing expertise with international teams to strengthen trauma care globally


You can also support IMPACT’s research by joining the Patient and Public Involvement group (PPI) where you will help to shape our future research projects.
Meeting online every 2–3 months, the group will be made up of people from different backgrounds, former patients and those who have personal
experience of road traffic collisions (RTCs) and road injury.
Your involvement might include helping to identify which research questions are most important to people affected by RTCs, sharing everyday perspectives to improve research ideas, or reviewing plain English summaries and other materials to ensure that they’re easy to understand.
































As the autumn days give way to the chilly and darker winter evenings, the changes in temperature, weather, and sunlight can really hinder our ability to drive safely on our roads, no matter what age we are, what level of experience we have or how confident we are in our driving skills.
It’s during these times that pedestrians, cyclists, and other road users are at higher risk. So whatever you’re driving, it’s best to be as prepared for these seasonal changes as possible.
If the weather forecast’s looking bad, it’s even more important to plan your journey in advance. Keep an eye on the weather for different places along your route, and if it looks particularly nasty, consider taking an alternative route. Also, remember that your car will likely use more fuel during winter. Don’t risk running out or letting that petrol needle get too low, as you could be in a bit of a pickle if you run out on a dark road or in bad weather.
During the winter months between November and February, our roads witness a surge in severe accidents, with nearly a quarter of the British population reporting involvement in car accidents after driving in challenging weather conditions.



During the winter months between November and February, our roads witness a surge in severe accidents, with nearly a quarter of the British population reporting involvement in car accidents after driving in challenging weather conditions.




We’ve compiled a set of simple DIY tips to help you prepare your vehicle for driving in the winter months. By using these checklists regularly, you’ll be better prepared to handle the roads during the winter months and throughout the year.
‘By failing to prepare, you are preparing to fail.’
- Benjamin Franklin
The acronym, ‘FORCES’ might help you to remember the regular ‘DIY checks’ you should undertake throughout the winter: Fuel, Oil, Rubber, Coolant, Electrics, Screen wash.
your windscreen with a blanket or sheet to keep it ice and snow free. Wrap the wipers in the sheet to avoid sticking. Alternatively, place a strip of plastic or card between the blades and the glass.


Make sure your car’s coolant level is correct when the engine is cold and especially before a long trip. If you need to top it up, remember, your car’s manual will have all the details you need.



Before you start your journey, check your fuel or battery charge levels. If you’re driving an electric car, check the charging points on your route to top up if needed.


It’s crucial to check your oil level regularly. If the oil level is low, top it up right away. You can find the type of oil you need in your owner’s handbook, by looking online or by talking to your local dealer.


Before you set off, check your tyres for wear and tear, cracks, bulges and tread depth. The minimum is 1.6mm, but it’s advisable to have 3mm during winter for better traction. Ensure your tyres are correctly inflated too - your owner’s handbook will have the correct levels. Check your wiper blades for splits and cracks. Use de-icer or warm water (never hot water!) to free them if necessary. Cover


Check your car’s lights, they get extremely dirty during the winter months, so make sure all are free from dirt, grime, and snow. If your car struggles to start when you turn the key, get it checked at a garage. Cold weather puts extra strain on batteries, requiring them to work harder to cope with increased demand from electrical equipment like lights and heaters.


Wintery conditions bring more muck and dirt on the roads, along with salt, so it’s crucial to keep your windscreen clean. Check and top up the screen wash level as you use it. Make sure it’s effective down to at least -15ºc, so you don’t have any problems with an icy windscreen.






Vision Zero’s free DRIVE ON magazine contains lots of great motoring features to help you stay safe, get the most out of your car and keep driving for longer.





















Earlier this year, we marked the 8th anniversary of our much-loved Dragon Boat Festivaland once again it delivered a fantastic day of fun, teamwork, and community spirit!
Thirteen enthusiastic teams took to the River Exe at Exeter Quay for a day packed with racing, laughter, and friendly rivalry. Many of these teams were local businesses, keen to do something meaningful with their colleagues while supporting a vital local cause.
This year’s champions were Teign Trees, with Nest Associates taking second place and Tool Care Hire, Exeter securing third. Every team brought energy and enthusiasm, helping to keep the competitive spirit of the festival alive. A heartfelt thank you to all who took part - your support helps Devon Air Ambulance continue to deliver time-critical care across Devon, every single day. Over the years, the Dragon Boat Festival alone has raised £143,506, thanks to the enthusiasm of all our the amazing participants – many of whom are corporate supporters.
Our corporate partners play a crucial role in sustaining our lifesaving mission. By partnering with us, your business directly contributes to the emergency care we provide to hundreds of patients each year.
Getting involved in events like the Dragon Boat Festival is a brilliant way to engage your team while making a real difference. Whether you’re racing on the water or volunteering on the day - perhaps by running a donation station - there are countless creative and impactful ways your business can support Devon Air Ambulance.
Tracy Hepper, DAA Corporate Partnership Manager welcomes corporate support:
“Partnering with us not only celebrates social responsibility, but it also fosters a sense of pride and unity among employees who fundraise and volunteer for us, strengthening and building goodwill within the local community.”
Ways to support a charity partnership:
• Employee fundraising
• Strategic partnerships
• Challenge events
• Cause-related marketing & commercial collaborations
• Payroll giving
• Match funding
• Sponsorship opportunities
The Dragon Boat Festival will return on 21 June, 2026...
So why not start rallying your crew now?


Staff at Perrigo Braunton are making a difference one cake sale, one chest compression, and one heartfelt donation at a time.
Perrigo is a leading self-care company - with over a century of experience in providing high-quality health and wellness solutions to consumers primarily in North America and Europe – and also a proud supporter of Devon Air Ambulance. Since acquiring Wrafton Laboratories in Braunton in 2001, the company has enhanced its facilities, along with its commitment to the local community.
That commitment has translated into over £34,000 raised for our charity - an incredible achievement that’s helped us deliver time-critical care across Devon. Last year, Perrigo raised more than £8,000, which enabled us to purchase a new LUCAS device, a mechanical chest compression system that can be attached to a patient in cardiac arrest to deliver consistent, high-quality CPR. But it’s not just the big numbers that matter, it’s the spirit behind them.
Earlier this year, Perrigo colleagues rolled up their sleeves and tied on their aprons for our Bake Off for Take Off campaign. Their homemade creations, shared and sold among staff, raised nearly £200, proving that even the smallest gestures can make an enjoyable – and delicious impact..

A group of Perrigo staff recently visited one of our airbases to see the LUCAS machine in action. They took part in CPR and defibrillator training, gaining hands-on experience and a deeper understanding of how their support translates into real-world impact.
Charmaine McIntosh of Perrigo shared: “Devon Air Ambulance holds a special place in the hearts of many colleagues at Perrigo Braunton. Over the years this incredible charity has provided vital support to friends and family members within our community, and we are truly grateful for the lifesaving work they do.
“As a team at our Perrigo Braunton site, we’ve proudly raised funds to support Devon Air Ambulance through initiatives like Bake Off for Take Off and by selecting them as our partner charity for two consecutive years. This choice, made by our own staff, is a testament to the admiration and appreciation we have for the dedication and hard work of the Devon Air Ambulance charity. Thank you for all you continue to do to save lives across Devon.”
From baking to training, Perrigo’s partnership is a great example of how businesses can make a difference. We’re incredibly grateful for their continued support.
Join Perrigo in supporting us
Download our Business Supporters’ Pack at: daat.org/corporate or contact Tracy at t.hepper@daat.org to find out how your company can get on board.













What began as a routine DIY project suddenly turned into a life-threatening emergency.


alph was enjoying a quiet day at home, tackling a few DIY jobs. Armed with an angle grinder fitted with a circular saw blade, he was trying to cut through some stubborn lengths of timber. But in a split second, things went badly wrong. The blade snagged, kicked back violently, and spun out of control - cutting into Ralph’s left arm from his wrist to his elbow. His resulting injury was serious and needed urgent medical attention.

“I had this really calm moment where I just looked at my arm and thought, ‘that is horrendous’’’, Ralph recalled. His wife was in the kitchen when he walked in and calmly stated that he’d, ‘Had a bit of an accident’. Quickly stemming the bleeding with a tea towel, she called the emergency services before turning off the angle grinder, which was still buzzing upstairs and had cut through the floor and adjacent radiator, leaking water everywhere.
Advanced Prehospital Practitioner, Andy Dunne, arrived shortly after the land ambulance crew and administered intravenous morphine and antibiotics to Ralph to ease any pain that might occur as the adrenaline wore off, and to minimise the risk of infection. “The weird thing is, it didn’t really hurt,” said Ralph. “I think because it was such a large blade, it left quite a clean cut. There was a throbbing sensation, but I wasn’t in a lot of pain.”
Ralph was transported




to the Royal Devon and Exeter (RD&E) Hospital by land ambulance with Andy accompanying him. Andy called ahead to alert the receiving hospital team, and, upon arrival, the duty Plastic and Vascular Surgeons were there to assess Ralph immediately. Despite the chaos, he recalls feeling surprisingly relaxed thanks to Andy. “Andy is a great guy. He kept me really calm the entire journey and was telling jokes that kept me smiling.”












At hospital, an x-ray revealed severe damage to his muscles, bone and tendons, but the angle of the blade had ultimately saved Ralph’s arm.
While a plastic surgeon examined the injury, Andy chatted to Ralph about his work and hobbies, and Ralph explained his love for playing the bass guitar. The surgeon reassured him, “We’ll be able to put you back together and fix your arm. We hope that in time you will be able to play guitar again.”
At 6pm that evening, Ralph underwent a 4-hour surgery where the plastic surgeon meticulously reattached his tendons and nerves.
“When I woke up, my whole left arm was in plaster,” Ralph said. “I kept touching my fingertips with my right hand to see if I had any feeling. I was lying there thinking that I might need to sell my guitar and go back to playing the drums. I was preparing myself.”
Despite the uncertainty, Ralph found solace by running through scales and chords in his mind. About a week later, he returned to the hospital to have his plaster cast removed and his arm placed in a custom-moulded splint. “They were wonderful people,” Ralph recalled. “Everyone was so nice! Seeing the cut and scar for the first time was a shock.”
Ralph spent six weeks with his arm in the splint and a sling, while undergoing physiotherapy sessions. “The physio was unbelievably brilliant,” he said. “By doing exactly as I was told, it made a huge difference to my recovery. At my last session, they told me I had healed really quickly and didn’t need any more physio.” One Sunday in August, Ralph was surprised by a visit from Andy. “It made me tear up,” Ralph said. Andy asked if he could play guitar again, and Ralph brought out his classical guitar and played for him. “We both got quite emotional. All my friends are guitarists and musicians; it’s a huge part of my life. During my recovery, I couldn’t even listen to music. It was heartbreaking, and we had to postpone many gigs. My determination to recover was driven by my desire to play in my band again. Without Andy insisting I go to RD&E, I don’t know if I would be playing now!”


Andy later attended Ralph’s first gig playing guitar again. Andy said, “It was a privilege to be part of the wider team treating Ralph, and I am so pleased to see the remarkable recovery he has made. A large part of this is down to his own determination and persistence with his physiotherapy and daily exercises – a bespoke package was tailored for him to help his tendons, muscles and nerves to heal, and playing guitar matched the exercise and necessary range of motion. It is a real pleasure to see Ralph doing what he enjoys – he plays a mean bass!”



Nobody expects to need our specialist medical help, but throughout our 30-year history, over 31,000 people have. The personal account of your experience will be incredibly powerful in encouraging more people to support our charity.
With your approval and agreement, your story may feature in our Helipad magazine, on our website, or in other media.
If we’ve helped you or a family member and you would like to share your story with us, please complete the form at the website address below or scan the QR code and a member of our team will be in touch to have a chat.
Learn more about the different types of mission that we attend, visit www.daat.org/mission-map




Thank you to crossword enthusiasts who entered our Spring/Summer 2025 crossword competition. Andy McGlen from Buckfastleigh was the winner of a St Austell Brewery voucher worth £50, generously donated by the brewery.



This issue, the lucky winning entry will receive a family return ticket for a family of four (2 adults, 2 children) from Exeter Cruises for a wonderful day out sightseeing.
1 Small archipelago off the south-west tip of Cornwall (6)
4 RHS gardens near Torrington (8)
10 Smelling strongly or unpleasantly (7)
11 Mischievous or cheeky youngsters (7)
12 Edith, French singer (4)
13 Second city, famous for its Jewellery Quarter (10)
15 A lover of food and wine (9)
16 The internal organs of an animal, like the liver or kidneys (5)
18 A principle or belief (5)
19 Bodily organs that synthesise substances directly into the bloodstream (9)
21 A paper seller (10)
23 Among, surrounded by (4)
26 Very stupid behaviour (7)
27 A unit of energy in food (7)
28 A person who goes naked wherever possible (8)
29 Victoria, BBC Spotlight presenter (8)
1 A thick, sweet, sugary liquid (5)
2 A repetitive process or utterance (9)
3 A place where a dangerous wild animal might live (4)
5 A rower (7)
6 Dwight D., 34th President of the USA (10)
7 Town in Northern Ireland (5)
8 Looks like (9)
9 Catch fire (6)
14 A person who grows something (10)
15 A part that is added, perhaps to a house (9)
17 Way of forcing someone to walk, often with arms pinned behind them (9)
19 A tribe of native Americans who lived in New York State (7)
20 A decision made between two or more things (6)
22 Usually narrow part of body between ribs and hips (5)
24 A story in your head while asleep (5)
25 To make indistinct or fuzzy (4)























Complete the crossword to reveal the letters in the shaded boxes – simply solve the anagram to identify a word relating to DAA.
Enter online at www.daat.org/crossword or by writing your name, contact details and the answer on a postcard and posting to : The Editor, Helipad Crossword Competition Autumn/Winter 2025, Devon Air Ambulance, 5 Sandpiper Court, Harrington Lane,
The competition is free to enter, one entry per person.
The closing date for entries is midnight on 30 March 2026 when the successful winning entry will be selected at random.
Full Terms and Conditions can be found at: www.daat.org/crossword or by writing to The Editor at the above address

Your generous support keeps crews responding. Sign up today and receive a complimentary Devon Air Ambulance pin badge and show your support with pride.
There are many ways to contact the team at Devon Air Ambulance:
daat.org – You’ll find lots of information about the charity and our service on our website.
If you’ve been airlifted or helped by us, go to our Your Patient Story page and tell us your story. daat.org/your-story
For all sorts of fundraising advice and event information, visit our Get Involved pages. daat.org/fundraising
Instruction to your bank or building society

Please pay Devon Air Ambulance Regular Direct Debits from the account detailed in this Instruction subject to the safeguards assured by the Direct Debit Guarantee. I understand that this Instruction may remain with Devon Air Ambulance Regular and, if so, details will be passed electronically to my bank/building society.
If you’ve been assisted by DAA, and want to thank the crew visit our Thank the Crew page on our operational website. daatcl.co.uk/thank-the-crew
Name and full postal address of your Bank or Building Society To: The Manager of
Society
Signature(s)
Date
instructions from some types of account Branch sort code
Please now complete your details below
Name
Telephone Email
I wish to give Devon Air Ambulance Trust a donation of £ per month/quarter/year (delete as appropriate)
Please take Direct Debits on 6th/20th of the month (delete as appropriate)
I wish to give Devon Air Ambulance Trust a donation of £ per month/quarter/year (delete as appropriate)
Please take Direct Debits on 6th/20th of the month (delete as appropriate)
We take your personal data seriously and do not sell on or share with any third party. If you would like to receive our Helipad magazine or occasional information about the Charity please tick: Post Email
We take your personal data seriously and do not sell on or share with any third party. If you would like to receive our Helipad magazine or occasional information about the Charity please tick: Post Email Telephone SMS Message
I want to Gift Aid my donation of £ ___________ to Devon Air Ambulance
I want to Gift Aid my donation of £ ___________ and any donations I make in the future or have made in the past 4 years to Devon Air Ambulance
Please notify the charity if you:
Please notify the charity if you:
• Want to cancel the declaration
• Want to cancel the declaration
• Change your name or home address
• Change your name or home address
• No longer pay sufficient tax on your income and/or capital gains
• No longer pay sufficient tax on your income and/or capital gains
I confirm I am a UK taxpayer and understand that if I pay less Income Tax and/or Capital Gains Tax in the current tax year than the amount of Gift Aid claimed on all my donations it is my responsibility to pay any difference.
I confirm I am a UK taxpayer and understand that if I pay less Income Tax and/or Capital Gains Tax in the current tax year than the amount of Gift Aid claimed on all my donations it is my responsibility to pay any difference.
The Direct Debit Guarantee
• This Guarantee is offered by all banks and building societies that accept instructions to pay Direct Debits.

• If there are any changes to the amount, date or frequency of your Direct Debit Devon Air Ambulance Regular will notify you five (5) working days in advance of your account being debited or as otherwise agreed. If you request Devon Air Ambulance Regular to collect a payment, confirmation of the amount and date will be given at the time of the request.
• If an error is made in the payment of your Direct Debit, by Devon Air Ambulance Regular or your bank or building Society, you are entitled to a full and immediate refund of the amount paid from your bank or building society.
• If you receive a refund you are not entitled to, you must pay it back when Devon Air Ambulance Regular asks you to.
• You can cancel a Direct Debit at any time by simply contacting your bank or building Society. Written confirmation may be required. Please also notify us.
This guarantee should be detached and retained by the payee






























































Same great prizes. Same lifesaving impact. Brand new look.
We’re thrilled to unveil the exciting new brand for our much-loved lottery! While the design has had a makeover, everything you love about the lottery remains exactly the same, the weekly prizes, the fun, and the incredible difference you make with every entry.
This fresh new look reflects the energy and passion of our supporters, people like you who help save lives every single week.
Know someone who’d love to join the fun? Invite them to play and you’ll both receive a free gift as a thank you!
Here’s how it works:
Add your name and postcode to the form opposite.
You’ll both receive a complimentary gift! 1 2 3 4
Ask your friend to complete the rest.
They’ll be entered into the weekly draw.
Upgrade your direct debit today for even more chances to win — and to help us raise more vital funds.
• Call our Lottery Team on 01392 466666 - option 3
• Or speak to one of our friendly canvassers
• Learn more at daat.org/lottery







DAAT Lottery Office, 5 Sandpiper Court, Harrington Lane, Exeter EX4 8NS
DAAT Lottery Office, 5 Sandpiper Court, Harrington Lane, Exeter EX4 4NS
Tel: 01392 466666 Option 3 or email lottery@daat.org
The above postal address is all you need when contacting us by post.
Staff ID Number HP09/25
Your Details PLEASE COMPLETE IN FULL - BLOCK CAPITALS PLEASE
StaffI/DNumber
Mr/Mrs/Miss/Other
First Name
Mr/Mrs/Miss/Other
Surname
FirstName
Date
Surname
DateofBirth
Address
Lottery Membership Application
Thesumof(tickoneboxonly)
1 Chance
The sum of (tick one box only) 1 Number 2 Numbers
£4.34 Monthly
£13.00 Quarterly
£26.00 Six Monthly
£52.00 Annually
2 Chances
£8.68 Monthly
£26.00 Quarterly
£52.00 Six Monthly
NB: Monthly subscription first payment is £5 per number
£104.00 Annually
Payments to be paid on either 6th, 13th, 20th or 27th of each month FOR OFFICIAL USE ONLY
Official Use Only
First payment due immediately and thereafter on 6th or 20th of each month.
YourDetails PLEASECOMPLETEINFULL-BLOCKCAPITALLETTERS
Please fill in the form and send to:
DAAT Lottery, 5 Sandpiper Court, Harrington Lane, Exeter EX4 8NS.
Name and full postal address of your bank or building society

Referer/Current Players Name Referers postcode
Postcode Telephone Email HP1116
I confirm I am 16 years of age or over
I Confirm I am 16 yrs of age or over
Cheque payment - amount received £ ......................
Cheque Payment - Amount Received £..................
For entries @ £1 per week per entry
For entries @ £1 per week per entry
Lottery promoted by Devon Air Ambulance Trust. Devon Air Ambulance Trust is licensed by the Gambling Commission, Number 000-0005032-N-308657-001.
Responsible person: D Hawes www.gamblingcommission.gov.uk
Please gamble responsibly. For advice visit www.gambleaware.co.uk
DAAT is a member of the Lotteries Council and is committed to promoting a responsible approach to gambling. Contact us at : T: E: lottery@daat.org www.daat.org
466666 Option 3
Administration Office: DAAT Lottery Office, 5 S andpi p er Court, H ar r i ngt o n L an e, Ex eter EX4 8 NS
You will shortly receive a letter from us showing your lucky number/s. There is no need to claim as all prizes are paid automatically.
All proceeds go to support the Devon Air Ambulance Trust, charity No 1077998. Your subscription is greatly appreciated as our lottery raised over £2.5m in 2024 which helps to keep our crews responding. We receive no funding from either the Government or the National Lottery. We rely on your support, to help us to continue our essential lifesaving service.
Results are published every Friday afternoon on our website at: www.daat.org.
Thank you for your support - you are truly making a difference.




•Allcustomerfundsintendedfortheuseinfuturegamblingandorlotterysubscriptionswillbeheldinaseparatebank account or accounts relating to the
affiliated
lottery and will be completely separate from the Charity’s trading income.
•Wearerequiredbyourlicencetoinformcustomersaboutwhathappenstofundswhichweholdonaccountforyou,and the extent to which funds are protected in the event of insolvency. www.gamblingcommission.gov.uk/consumers/protection-of-customer-funds.aspxWeholdcustomerfundsseparatefrom Charity’s funds. This means that steps have been taken to protect customer funds but that there is no absolute guarantee thatallfundswillberepaid.ThismeetstheGamblingCommission’srequirementsforthesegregationofcustomerfunds at the level: medium protection.
•Thelicenseeoperatesastrictno‘cashpolicy’topreventtheriskofcrimessuchasmoneylaundering,toavoidthegiving of illicit credit and to provide assurances that gambling activities are being conducted fairly.
of the terms and conditions please call 01392 469886.
This Guarantee should be retained by the payer.
• This Guarantee is offered by all banks and building societies that accept instructions to pay Direct Debits.

This Guarantee is offered by all banks and building societies that accept instructions to pay Direct Debits
Ifthereareanychangestotheamount,dateorfrequencyofyourDirectDebitPSLre DAAT Lottery will notify you 5 working days in advance of your account being debited orasotherwiseagreed.IfyourequestThePSLreDAATLotterytocollectapayment, confirmationoftheamountanddatewillbegiventoyouatthetimeoftherequest
• If there are any changes to the amount, date or frequency of your Direct Debit DAAT Lottery will notify you five (5) working days in advance of your account being debited or as otherwise agreed. If you request DAAT Lottery to collect a payment, confirmation of the amount and date will be given to you at the time of the request.
If an error is made in the payment of your Direct Debit, by PSL re DAAT Lottery or your bank or building society, you are entitled to a full and immediate refund of the amount paid from your bank or building society
• If an error is made in the payment of your Direct Debit, by DAAT Lottery or your bank or building society, you are entitled to a full and immediate refund of the amount paid from your bank or building society.
– If you receive a refund you are not entitled to, you must pay it back when PSL re DAAT Lottery asks you to.
- If you receive a refund you are not entitled pay it back when DAAT Lottery asks you to.
You can cancel a Direct Debit at any time by simply contacting your bank or building society.Writtenconfirmationmayberequired.Pleasealsonotifyus.
• You can cancel a Direct Debit at any time by simply contacting your bank or building Society. Written confirmation may be required. Please also notify us.
DAA would like to keep you informed about our work, how your support has helped to keep our helicopters in the air and how you can be involved in the future. We take the protection of your personal information very seriously and don’t share your data with any third party. If you would like to receive our Helipad magazine or occasional information about our charity please tick the relevant boxes below: Please contact me by email Please contact me by post Please contact me by telephone Please contact me by SMS message
To read our Supporter Promise: Visit www.daat.org/supporter-promise or to request a copy, email fundraising@daat.org or ring 01392 466666
To read our Privacy Statement: Visit www.daat.org/gdpr-statement or, to request a copy, email: fundraising@daat.org or ring 01392 466666
We would like to use winners name and general location for our weekly results on our website/poster. Please tick here if you are happy for us to use this information

Turn your purchases into lifesaving donations with ‘easyfundraising’.

s the festive season approaches, many of us are busy making lists (checking them twice) and hunting for that perfect gift. But what if your Christmas shopping could do more than just bring smiles to the faces of your loved ones? What if it could support your local community at the same time?
This Christmas, you can help Devon Air Ambulance - at no extra cost - by doing your online shopping through easyfundraising.org.uk.
Easyfundraising is a free-to-use website that turns online purchases into free donations for your chosen cause. With over 8,000 retailers to choose from, including, John Lewis, Marks & Spencer, Amazon, Argos


and Etsy, they’ve got Christmas covered! When you shop via the easyfundraising website or app, a percentage of what you spend can be donated to Devon Air Ambulance - without costing you a penny more.
It’s a simple yet powerful way to give back during the season of goodwill. Whether you’re buying gifts, decorations, festive food, or even booking travel, every purchase could help keep Devon’s emergency helicopters flying and critical care cars on the road.
By using easyfundraising, you can support our essential service this winter. Your support will allow us to keep reaching patients quickly, while bringing specialist care to the scene during the winter months when weather conditions can delay traditional emergency services.
Visit easyfundraising.org.uk/causes/devonairambulance
Click “Support this cause”
Shop online using the easyfundraising portal or app









This Christmas, let your shopping do something extraordinary. Support Devon Air Ambulance through easyfundraising and help save lives across Devon - one gift at a time.



































